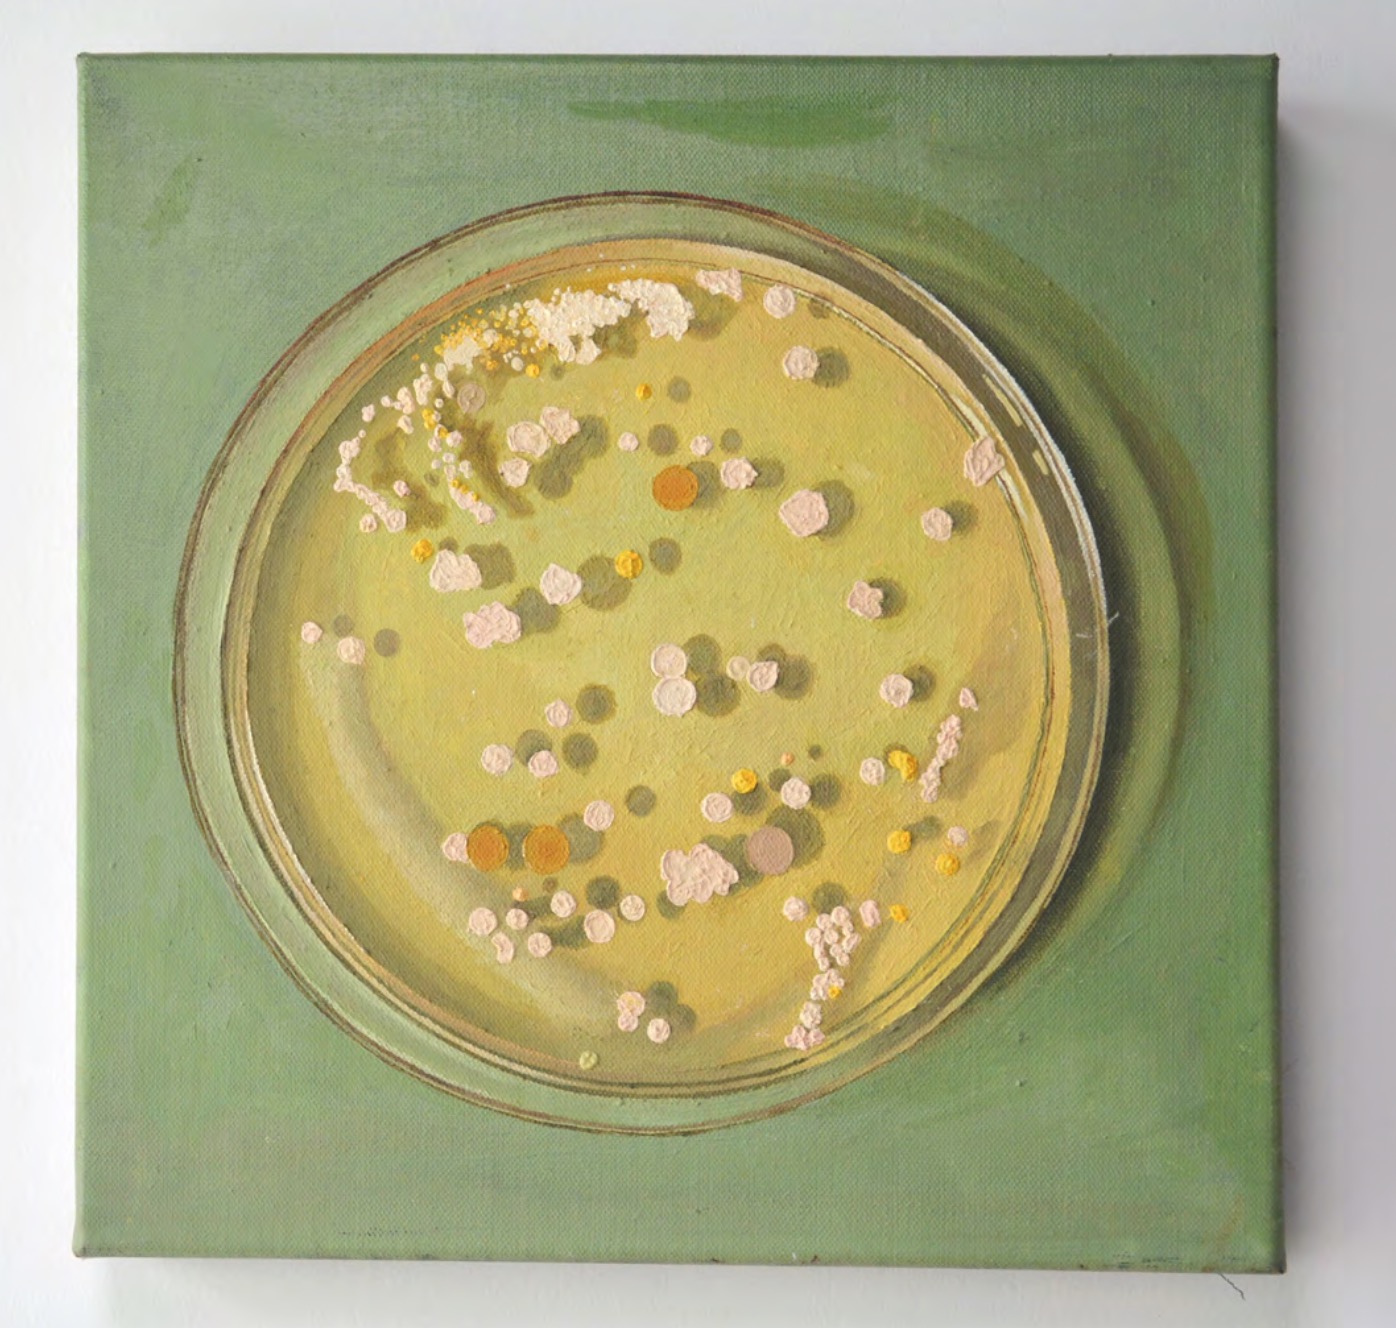
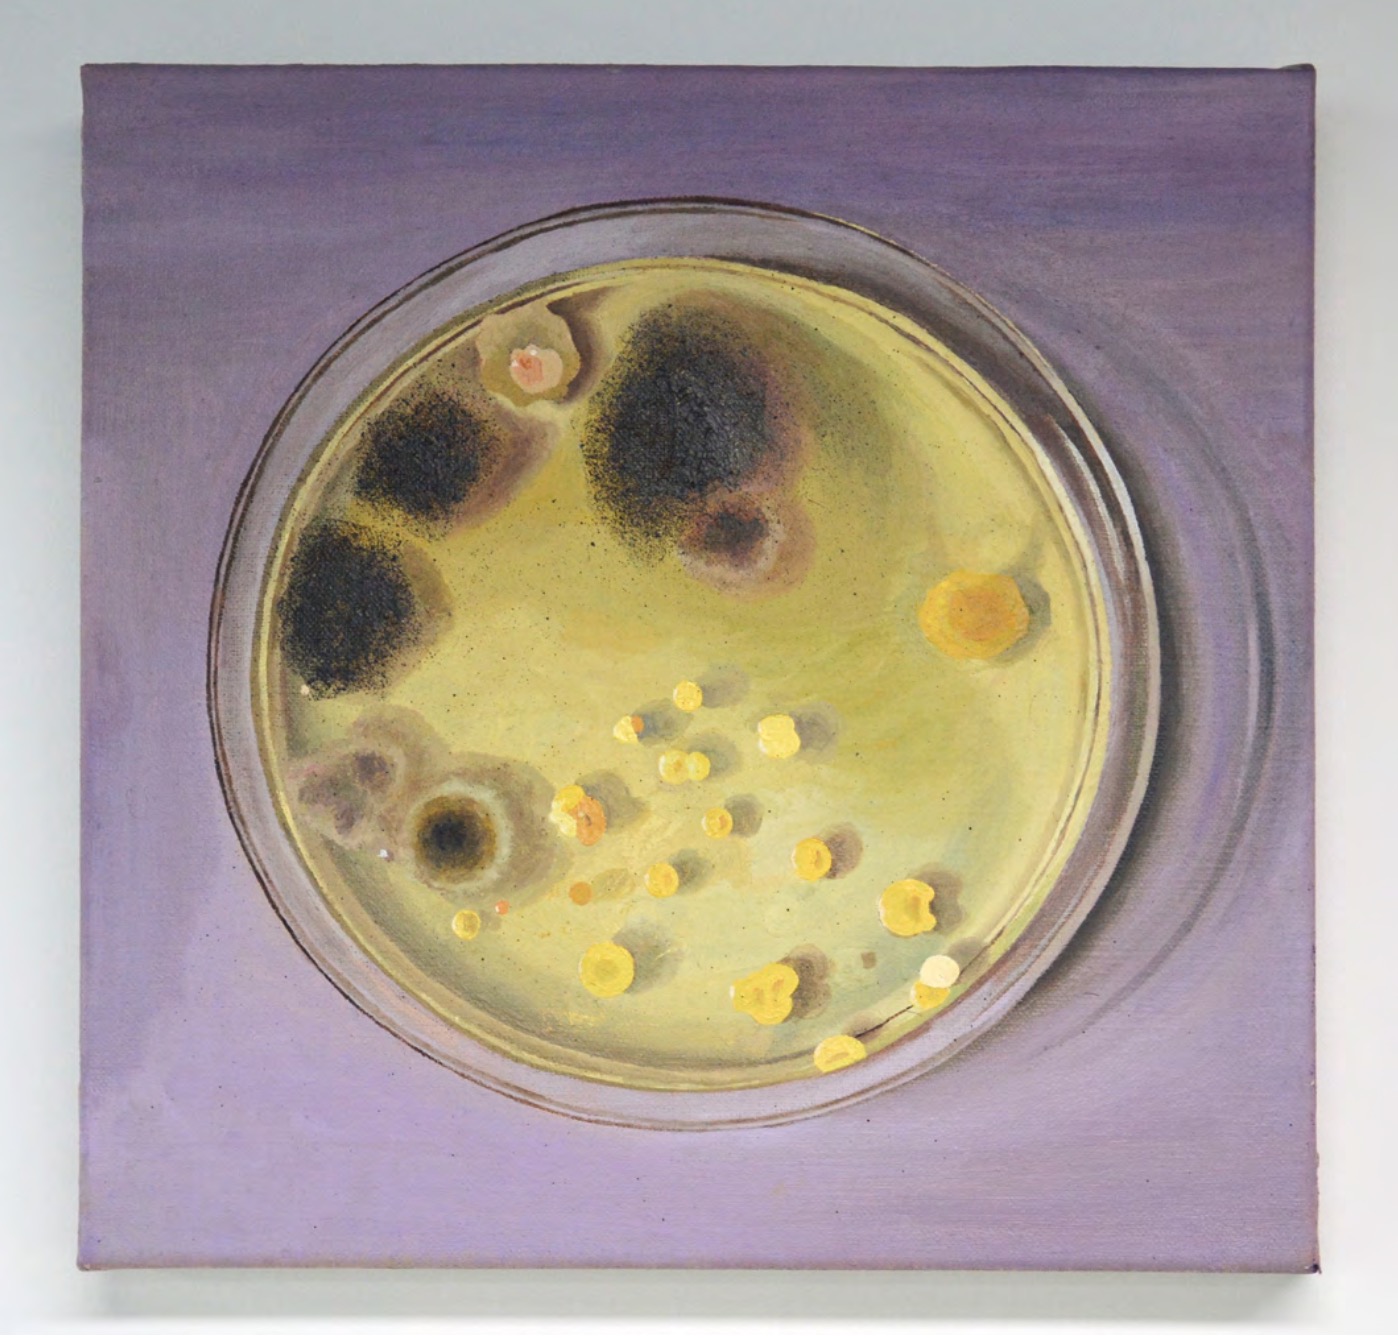
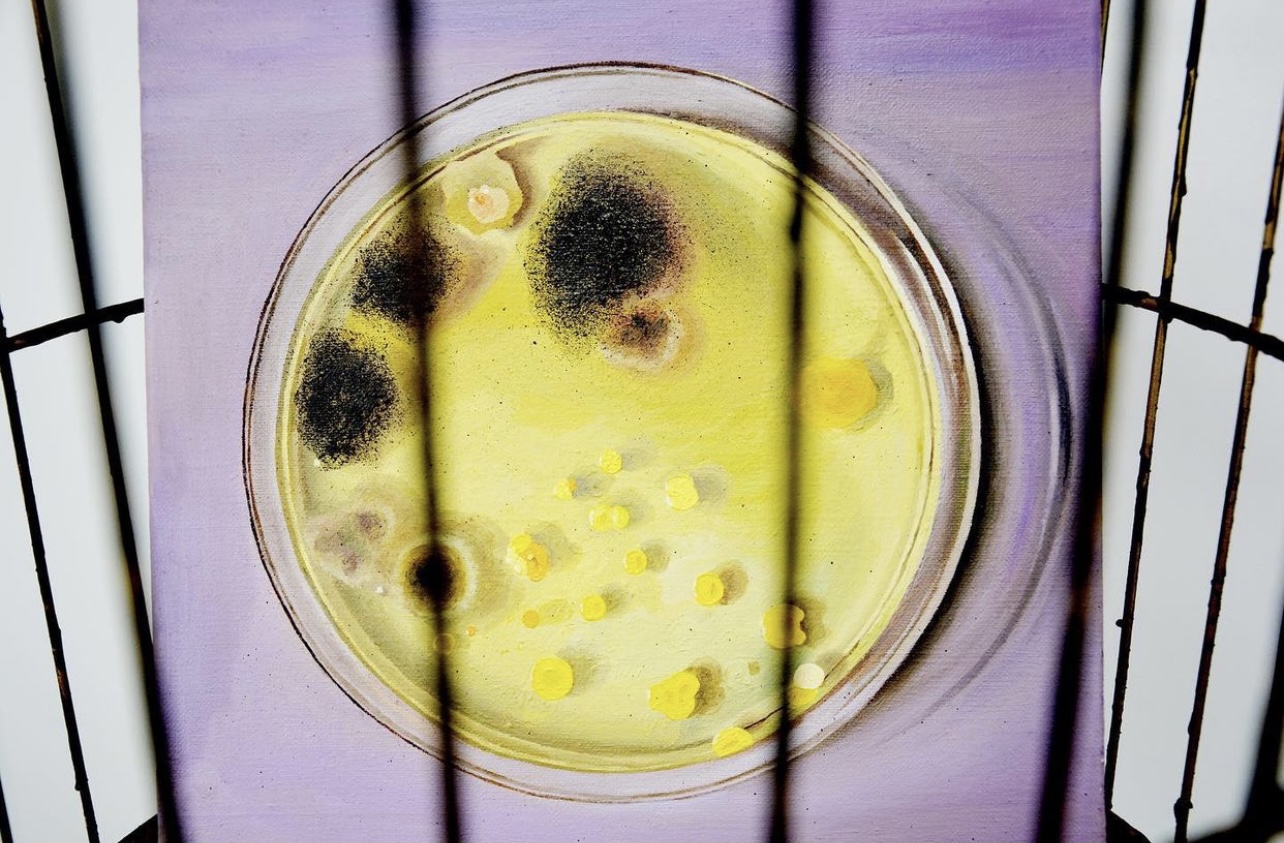

Micro world: daily fresh pure milk 1
Oil on canvas
35 x 35 cm
2019

Micro world: daily fresh pure milk 2
Oil on canvas
35 x 35 cm
2019
Micro world: five yuan coin 1
Oil on canvas
35 x 35 cm
2019

Micro world: five yuan coin 2
Oil on canvas
35 x 35 cm
2019

After COVID-19, people often get nervous at the mention of bacteria. Bacteria are so ubiquitous that they've always been around and even play an important role. So l became interested in bacteria in the micro world that we can't see directly with the naked eyes.
In this work, l experimented with cultivating bacteria in our lives, depicted the obtained images in oil paintings, and displayed them with installations. l want to turn the micro world neglected by people into paintings that can be appreciated to establish a visual connection between the biological world of bacteria and human beings.




Bacteria,an ancient creature that exists whereverthere is life,can be carried from one place toanother by air currents and vary significantly in sizeand shape. For the environment, bacteria candecompose and recycle plant and animal wasteand enter the food chain again.
Biologically speaking,more than one hundredtrillion symbiotic bacteria live in the human bodyThese bacteria help us block the invasion of harmfubacteria and produce essential nutrients. They canalso enhance immunity and maintain the body'snormal functions.
Therefore, there is no need to be nervous even atthe mention ofbacteria because they areeverywhere and essential to us, and we can't livewithout them.
Bacteria Cultivation
With a better understanding of bacteria, l began to further my exploration of different bacteria with my curiosity. To learn more about bacteria, l did a small experiment to cultivate different bacteria around us to observe their different forms as they grew.
Steps
1. Prepare the agar
2. Prepare the Petri dishes
3. l collected four types of bacteria (bacteria on coins, bacteria in expired milk, bacteria on bus handrails, bacteria on mouldy bread)Direct contact inoculation: l put such bacteria-laden objects as coins, expired milk, and mouldy bread in direct contact with the culture medium. Sample collection inoculation: l dipped some dust on the bus handrail with a cotton swab and then smeared it on the surface of the culture medium.
4. Label and seal the Petri dishes
5. Put the Petri dishes in a warm and dark place for cultivation for four days, thus the bacteria can reproduce and grow well.
After four days, each petri dish was full of various microorganisms in different forms. In the process, l took pictures of the organisms in the Petri dishes with a camera to record their growth forms.






With a better understanding of bacteria, l began to further my exploration of different bacteria with my curiosity. To learn more about bacteria, l did a small experiment to cultivate different bacteria around us to observe their different forms as they grew.
Steps
1. Prepare the agar
2. Prepare the Petri dishes
3. l collected four types of bacteria (bacteria on coins, bacteria in expired milk, bacteria on bus handrails, bacteria on mouldy bread)Direct contact inoculation: l put such bacteria-laden objects as coins, expired milk, and mouldy bread in direct contact with the culture medium. Sample collection inoculation: l dipped some dust on the bus handrail with a cotton swab and then smeared it on the surface of the culture medium.
4. Label and seal the Petri dishes
5. Put the Petri dishes in a warm and dark place for cultivation for four days, thus the bacteria can reproduce and grow well.
After four days, each petri dish was full of various microorganisms in different forms. In the process, l took pictures of the organisms in the Petri dishes with a camera to record their growth forms.
Sketches
Making Process



Making Process




